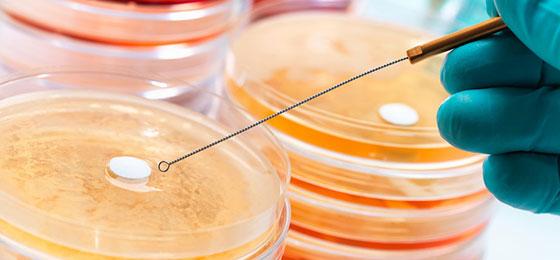

Vier internationale Projekte neu im NFP 72
Das NFP 72 beteiligt sich an länderübergreifenden Forschungsprojekten, die untersuchen, wie resistente Keime entstehen und sich verbreiten.
Das NFP 72 beteiligt sich neu an vier internationalen Forschungsprojekten, indem es deren Schweizer Teilprojekte unterstützt. Alle Projekte finden im Rahmen einer gemeinsamen Plattform von derzeit 22 Ländern statt. Die sogenannte Joint Programming Initiative on Antimicrobial Resistance (JPIAMR) will die Resistenzforschung international stärken.
Insgesamt werden nächstes Jahr 19 Projekte aus der dritten JPIAMR-Ausschreibung starten. Deren Fokus liegt auf der Frage, wie und wo antibiotikaresistente Keime entstehen und wie sie sich in Mensch, Tier und Umwelt verbreiten. Die Erkenntnisse sollen neue Möglichkeiten in der Prävention aufzeigen.
- JPIAMR
- Resultate der 3. Ausschreibung
- Bewilligte Projekte
